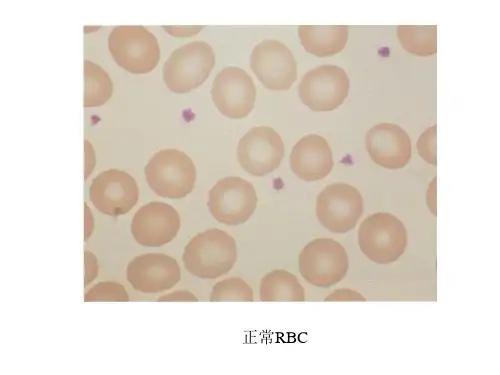

管型图片
- 格式:docx
- 大小:471.03 KB
- 文档页数:10



管型名词解释医学嘿,朋友!今天咱们来聊聊医学里的管型。
您知道吗?这管型在医学里就像是身体里的小“信使”,它们能透露很多关于咱们身体内部的秘密。
管型啊,简单说,就是在肾脏形成的一些有形状的东西。
这就好比是工厂里生产出来的特定产品。
您想想,如果工厂的生产流程出了问题,那生产出来的产品是不是就会不正常?肾脏也是一样,如果它的工作不正常了,形成的管型就会有变化。
比如说,透明管型。
这就像是一块透明的小水晶,正常情况下数量不多,就像咱们生活里偶尔见到的小宝贝,数量少但珍贵。
可要是一下子出现好多,那可能就意味着肾脏有点儿“累”了,得注意休息调整啦!再说说红细胞管型。
这就好像是一群红色的小战士,整齐排列。
要是在尿液里发现了它们,那可不得了,很可能是肾脏在“喊救命”,也许是肾脏里面有炎症在捣乱呢!还有白细胞管型。
它们就像是一群白色的小卫士,要是大量出现,那多半是肾脏被细菌或者炎症“攻击”啦,身体在发出紧急信号呢!颗粒管型呢,就像是一些小小的颗粒聚在一起,要是它们增多,可能表示肾脏的过滤功能不太好了,就像筛子的网眼变大,不该漏的东西都漏出来啦。
蜡样管型,这名字听起来是不是有点特别?它们就像是一根根硬邦邦的小蜡烛。
一旦出现,那可真是个让人头疼的事儿,往往意味着肾脏的病情比较严重啦。
管型的出现和变化,就像是身体给咱们发的一封封神秘信件。
咱们得读懂这些信,才能及时发现身体里的问题,早点采取措施,把疾病这个“小怪兽”赶跑。
所以啊,别小看这些小小的管型,它们可是咱们了解肾脏健康的重要线索。
咱们可得多留意,多关心自己的身体,别让这些小“信使”带来坏消息却被咱们忽略啦!您说是不是这个理儿?。

正常人的尿常规检查是没有管型的极少发现(主要是透明管型)。
如果尿检经常发现管型,为肾脏有病的一种表现。
由于管型是在远端肾小管内由不同物质"铸造"而成的边缘光滑的圆状物体,好像由肾小管"模子"脱成随尿冲出来,管型可分为透明管型、红细胞管型、白细胞管型、颗粒管型、蜡状管型等。
了解各种管型的形成和意义,有助于认识病理变化和治疗时参考。
透明管型:是单纯蛋白质在肾不管内凝固而成的。
因为是一种变性的蛋白质,像凝固的蛋清一样透明,不含有其他成分。
在尿蛋白多时,有利于透明管型的形成,如常见于肾小球肾炎、肾病综合征。
另外,长期发烧、各种原因引起的肾缺血等也可见到。
正常人偶尔在剧烈运动后,亦可见少许透明管型。
红细胞管型:是尿蛋白与经细胞在肾小管内凝固在一起而形成的。
此管型常与镜下血尿同时存在。
常见于急性肾小球肾炎。
白细胞管型:尿蛋白与脱落的上皮细胞凝固在一起而形成。
管型内含有大量白细胞,表示肾脏有感染性病变,常见于肾盂肾炎。
上皮细胞管型:尿蛋白与脱落的上皮细胞凝固在一起面形成。
由于炎症肾小和上皮细胞脱落与肾小管内蛋白质凝固混杂其中。
常见于急性小球肾炎。
颗粒管型:为一种透明的蜡样形态,是由于尿蛋白在已经变形、增粗的远端肾小管内凝固而时间较久所形成的管型之分,后者常提示小和病变严重。
可见于肾炎、肾病综合征、肾硬化症等。
蜡状管型:为一种透明的蜡样形状,是由于尿蛋白在已经变形、增粗远端肾小管内凝固而时间较久所形成的管型。
可见于严重肾小和变性坏死,如慢性肾炎的晚期。
临订化验中比较少见1)细胞管型:①红细胞管型属病理性,表明血尿的来源在肾小管或肾小球,常见于急性肾小球肾炎、急性肾盂肾炎或急性肾功能衰竭。
②白细胞管型属病理性,是诊断肾盂肾炎及间质性肾炎的重要证据。
若尿内有较多此类管型时,更具有诊断价值,可作为区别肾盂肾炎及下尿路感染的依据。
③上皮细胞管型在尿内大量出现,表明肾小管有活动性病变。

尿管型的临床意义及图谱日期:2015-03-18 14:15:26 来源: 未知点击: 次1、透明管型:在正常人浓缩尿中偶尔可见到,12小时尿液中少于5000个。
↑透明管型(未染色)↑透明管型(染色)在剧烈运动,发热,麻醉,心功能不全时,肾受到刺激后尿中可出现透明管型,大量出现见于急,慢性肾小球肾炎,肾病,肾盂肾炎,肾瘀血,恶性高血压,肾动脉硬化等疾病,急性肾炎时透明管型常与其它管型并存于尿中,慢性间质性肾炎患者尿中可持续大量出现。
2、细胞管型:细胞管型(cellularcasts)为含有细胞成分的管型,按细胞类别可分为红细胞管型,白细胞管型及上皮细胞管型。
(1)红细胞管型(RsdCellCasts):尿中见到红细胞管型,提示肾单位内有出血,可见于急性肾小球肾炎,慢性肾炎急性发作。
↑红细胞管型血红蛋白管型也可见于血型不合输血后溶血后应时及急性肾小管坏死,肾出血,肾移植术后产生排异反应时,在系统性红斑狼疮及其它胶析性能疾病,肾梗死,肾静脉血栓形成等情况时红细胞管型也可能是唯一的表现。
(2)白细胞管型(leucocytescasts):常见于急性肾盂肾炎,间质性肾炎等,有红斑狼疮肾炎患者亦可见到。
↑白细胞管型(未染色)(3)肾上皮细胞管型(renalepithelialcasts):常见于肾小管病变如急性肾小管坏死,子痫,重金属,化学物质,药物中毒,肾移植后排异反应及肾淀粉样变性等。
↑肾上皮细胞管型有时管型中的细胞成分难以区别,可笼统称为细胞管型,必要时亦可借助化学染色来区别,在弥散性血管内凝血(DIC)时,尿中可出现血小板管型,可用相差显微镜或经抗血小板膜糖蛋白的McAb加以区别。
3、颗粒管型:可见于肾实质性病变,如急,慢性肾小球肾炎,肾病,肾动脉硬化等,药物中毒损伤肾小管及肾移植术发生异反应时亦可见到。
↑细颗粒管型↑粗颗粒管型4、肾功能不全管型(renalfailurecasts):又称宽大管型(broadcasts),可见于肾功能不全患者尿中,提示肾脏局部有严重尿液潴留,急性肾功能不全者在多尿早期这类型管型可大量出现,随着肾功能的改善而逐渐减少消失,肾功能不全管型出现于慢性肾炎晚期尿毒症时,常表示预后不良。

色素管型,那些重“色”的管型都是什么?色素管型?似乎我们没有听说过这个名词!其实尿液中各种有形成分都有着天然颜色,无论是细胞,管型,还是结晶。
有些管型有着比较淡的颜色,如透明管型、颗粒管型或蜡样管型,白细胞管型一般呈灰白色,红细胞管型则呈现红细胞/ 血红素的颜色。
我们在显微镜下观察有形成分的时候除了外形和结构外,其天然的颜色也是要关注的重要内容,有助于我们鉴别管型,及管型内部包含什么物质!采用相差显微镜也许不会很好的获得尿中有形成分的原始颜色,在某些成分的识别上也会受到限制。
好在许多相差显微镜和光学显微镜是一体的,可以同视野切换观察模式。
在查看尿沉渣的时候要切换不同模式,看看在光学显微镜下这些原始成分是什么颜色,那些管型、细胞和结晶的色彩,将有助于你识别这些成分。
或许现在许多图像法原理的尿液有形成分分析仪,多采用黑白图像或单色图像,而这些宝贵的原始颜色就丢失了,令人遗憾。
埃里克・拜沃特斯(Eric Bywaters)于1941 年出版的《英国医学杂志》上,在关于挤压综合征的病理报道上首次使用了“色素管型” 这一术语,他用肾活检的显微照片(图1)说明了色素管型的存在(由肌红蛋白引起)。
图 1 最早记录色素管型的文献中配合的图片目前为止关于色素管型主要存在下面三类:肌红蛋白管型血红蛋白管型胆红素 / 胆汁管型一、色素管型之肌红蛋白管型肌红蛋白管型多呈红棕色,但通常与红细胞或红细胞管型无关。
可在急性肾损伤(AKI)患者的尿液中发现,这些患者往往伴有严重的肌肉损伤,导致横纹肌溶解症。
AKI 的主要病理生理机制是肾血管收缩、血红素蛋白(heme-protein)直接诱导的细胞毒性和肾小管管腔内肌红蛋白管型的形成。
图 2 肌红蛋白管型,新鲜未染色的尿沉渣,放大倍率 100 倍,光学显微镜。
图3 肌红蛋白管型和尿酸/ 尿酸结晶管型(红箭头),新鲜未染色尿沉渣,放大倍数400 倍。
左:光学显微镜;中:相差显微镜;右:偏振光显微镜。
尿液管型大家好,我们是管型家族!人类定义我们是含蛋白质、细胞及其崩解产物等在肾小管、集合管内凝固而成的圆柱形蛋白凝聚体,是尿沉渣中最具有临床诊断价值的成分之一,我们的出现往往提示着人类肾实质性的损害,接下来的文章会把我们家族的形成、种类、形态、临床意义和管型检查的质量保证等进行总结归纳,希望能给临床和检验医生提供参考价值。
嘿嘿!人类已经发现我们的形成需要具备以下条件:01我叫小透儿(透明管型),是家族里其它管型的基本骨架,由肾小管分泌的T-H 糖蛋白和少量清蛋白在肾远曲小管和集合管内,由于浓缩(水分吸收)酸化(酸性物增加)和软骨素硫酸酯的存在,而凝聚、沉淀形成的圆柱体状物质。
我们无色透明、表明光滑,有时也可能有少许颗粒或少量细胞黏附在管壁外或包含其中。
健康人见到我可别害怕,我很淘气,我会钻到健康人的清晨浓缩尿中,但是数量很少很少……还有健康人剧烈运动、高热、全身麻醉时也可以见到我,此时的我临床意义并不大哦!但是如果我大量出现在尿液中,或是我和家族中其他管型碰在一起,人类可要警惕了,此时多见于肾实质性病变如肾小球肾炎、肾病综合征、急性肾盂肾炎、充血性心力衰竭、肾淤血及恶性高血压等。
02嗨!我们是大粒儿(粗颗粒管型A↑)和小粒儿(细颗粒管型B↓),对喽!我们统称为颗粒管型!当透明管型里颗粒超过其体积1/3时,就变成了在下。
我们的颗粒多来源于崩解变性的细胞残渣、血浆蛋白及其他物质,在不染色的尿液中我们常呈淡黄褐色或棕黑色,体积比小透儿通常要短而粗。
我们的出现人类决不能掉以轻心了!尿液中出现大粒儿、小粒儿多见于慢性肾小球肾炎、肾病综合征、某些原因(药物中毒等)引起的肾小管损伤等。
非肾病患者在剧烈运动后、发热或脱水时尿中偶尔也可出现小粒儿,但量很少,且都是一过性的。
03看看我们身体里有什么?没错,我们是细胞管型!含有红细胞的叫小红(红细胞管型),含有白细胞的叫小白(白细胞管型),含有上皮细胞的叫小皮(肾小管上皮细胞管型)。
【每日指南】化验室检查图谱—尿检,这些你都见过吗?
Veterinary Technician's Daily Reference Guide - Canine and Feline 2
前言
犬猫临床化验室技术图谱大合集,以连载的形式和大家分享。
建议保持关注,并分享给您的学习小伙伴们~
图4.64:上皮细胞、白细胞、红细胞、细菌。
图4.65:上皮管型。
图4.66:脂肪管型
图4.67:颗粒管型
图4.68:透明管型
图4.69:红细胞管型和红细胞
图4.70:白细胞管型
图4.71:蜡样管型
图4.72:无定形磷酸盐晶体
图4.73:无定形尿酸盐结晶和气泡
图4.74:无定形尿酸氨结晶和黏液丝
图4.75:胆红素结晶
图4.76:碳酸钙结晶
图4.77:二水草酸钙结晶
图4.78:胱氨酸结晶和气泡
图4.79:亮氨酸结晶
图4.80:磺胺结晶
图4.81:三联磷酸盐结晶
图4.82:酪氨酸结晶
图4.83:尿酸结晶
图4.84:肾上皮细胞
图4.85:鳞状上皮细胞
图4.86:移行上皮细胞
图4.87:上皮细胞、脂肪滴图4.88:狐膀胱毛细线虫卵图4.89:淀粉颗粒
图4.90:酵母菌
翻译:张旭銮
校对:VETLAND小明。
管型分类及意义管型是一种常见的形状,在各个领域都有着重要的应用。
根据不同的形状和功能,管型可以被分类为直管、弯曲管和多孔管。
这些不同类型的管型在工程、生物学、物理学等领域中都有着重要的意义。
直管是最简单常见的管型,其截面呈圆形或方形。
直管通常用于输送流体、气体或电线电缆。
它们在建筑、工业生产、交通运输等领域中起着关键作用。
在建筑中,直管用于排水系统、给水系统等,保障了建筑物的正常运行。
在工业生产中,直管用于输送原材料、半成品或成品,提高了生产效率。
在交通运输中,直管用于制作车辆的排气管道、油管道等,保障了交通工具的正常运行。
弯曲管是一种曲线形状的管型,用于改变流体或气体的运动方向。
弯曲管常见于管道系统中,如暖通空调系统、排水系统等。
弯曲管的设计和安装对系统的性能和效率有着重要影响。
合理的弯曲管设计可以减小系统的压力损失,提高系统的运行效率。
在暖通空调系统中,弯曲管的设计可以调节空气流动方向,保持室内空气的舒适度。
在排水系统中,弯曲管可以有效排除污水,保持环境清洁。
多孔管是一种具有多个孔洞的管型,用于过滤、分离或混合物质。
多孔管广泛应用于化工、生物医药、环保等领域。
在化工领域,多孔管用于分离混合物中的不同成分,提取目标物质。
在生物医药领域,多孔管用于制备人工器官、药物释放系统等,改善人类健康。
在环保领域,多孔管用于处理废水、废气等污染物,保护环境和生态系统。
总的来说,管型的分类及意义是多方面的,涉及到工程、生物学、物理学等多个领域。
不同类型的管型在不同领域中发挥着重要的作用,推动着社会的发展和进步。
因此,对管型的研究和应用具有重要意义,有助于解决各种实际问题,促进人类社会的可持续发展。
尿管型的临床意义及图谱
日期:2015-03-18 14:15:26 来源: 未知点击: 次
1、透明管型:在正常人浓缩尿中偶尔可见到,12小时尿液中少于5000个。
↑透明管型(未染色)
↑透明管型(染色)
在剧烈运动,发热,麻醉,心功能不全时,肾受到刺激后尿中可出现透明管型,大量出现见于急,慢性肾小球肾炎,肾病,肾盂肾炎,肾瘀血,恶性高血压,肾动脉硬化等疾病,急性肾炎时透明管型常与其它管型并存于尿中,慢性间质性肾炎患者尿中可持续大量出现。
2、细胞管型:细胞管型(cellularcasts)为含有细胞成分的管型,按细胞类别可分为红细胞管型,白细胞管型及上皮细胞管型。
(1)红细胞管型(RsdCellCasts):尿中见到红细胞管型,提示肾单位内有出血,可见于急性肾小球肾炎,慢性肾炎急性发作。
↑红细胞管型
血红蛋白管型也可见于血型不合输血后溶血后应时及急性肾小管坏死,肾出血,肾移植术后产生排异反应时,在系统性红斑狼疮及其它胶析性能疾病,肾梗死,肾静脉血栓形成等情况时红细胞管型也可能是唯一的表现。
(2)白细胞管型(leucocytescasts):常见于急性肾盂肾炎,间质性肾炎等,有红斑狼疮肾炎患者亦可见到。
↑白细胞管型(未染色)
(3)肾上皮细胞管型(renalepithelialcasts):常见于肾小管病变如急性肾小管坏死,子痫,重金属,化学物质,药物中毒,肾移植后排异反应及肾淀粉样变性等。
↑肾上皮细胞管型
有时管型中的细胞成分难以区别,可笼统称为细胞管型,必要时亦可借助化学染色来区别,在弥散性血管内凝血(DIC)时,尿中可出现血小板管型,可用相差显微镜或经抗血小板膜糖蛋白的McAb加以区别。
3、颗粒管型:可见于肾实质性病变,如急,慢性肾小球肾炎,肾病,肾动脉硬化等,药物中毒损伤肾小管及肾移植术发生异反应时亦可见到。
↑细颗粒管型
↑粗颗粒管型
4、肾功能不全管型(renalfailurecasts):又称宽大管型(broadcasts),可见于肾功能不全患者尿中,提示肾脏局部有严重尿液潴留,急性肾功能不全者在多尿早期这类型管型可大量出现,随着肾功能的改善而逐渐减少消失,肾功能不全管型出现于慢性肾炎晚期尿毒症时,常表示预后不良。
↑宽大管型
5、混合管型:混合管型指管型内同时含有不同细胞及其它有形成分,用巴氏染色法有助于识别,可见于肾移植后急性排异反应,缺血性肾坏死,肾梗死等患者,在急性排异反应时,可见到肾小管上皮细胞与淋巴细胞的混合管型。
6、脂肪管型:在脂肪管型(fattycasts)内可见大小不等折光很强的脂肪滴,亦可能嵌入含有脂肪滴的肾小管上皮细胞,可用脂肪染色鉴别,为肾小管损伤后上皮细胞脂肪变性所致可见于慢性肾炎及类脂性肾病,尤其是多见于肾病综合征时。
↑脂肪管型
↑马耳他交叉现象
7、蜡样管型(waxycasts):在肾单位慢性损害,长期少尿或无尿的情况下,由颗粒管型或细胞管型等长期滞留于肾小管中演变而来,是细胞崩解的最后产生;也可由发生淀粉样变性的上皮细胞溶解后逐渐形成,在低渗溶液,水及不同的pH介质内均不溶解,它的出现提示肾小管的严重病变,预后差,可见于慢性肾小球肾炎晚期,肾功能不全及肾淀粉样变性时;亦可在肾小管炎症和变性,肾移植慢性排异反应时见到。
↑蜡样管型(未染色)
8、细菌管型(bacterialcasts):常见于肾脓毒性疾病,真菌管型可见于真菌感染时,但辨认困难,常需用细菌学及特殊染色等手段识别,发现此类管型,可早期诊断原发性及播散性真菌感染,对抗真菌药物的药将近监测有一定作用。
9、结晶管型:指管型透明基质中含尿酸盐或草酸盐等结晶,临床意义类似相应的结晶尿,如管型中含小圆形牙齿酸钙结晶时易被误作为红细胞管型,应注意仔细观察,也可应用细胞化学染色来区别。
10、类管型:粘液丝及与管型相似的物质
(1)类管型(cylindroidscasts):类圆柱体形态与管型相似,但其一端尖细扭曲或弯曲发螺旋状,因常与透明管型并存,可在急性肾炎病有尿中见到,与肾血循环障碍或肾受刺激时有关医学教|育网搜集整理。
(2)粘液丝(mucousstrands):为长线条形,边缘不清,未端尖细卷曲,可见于正常尿中,如大量存在的常表示尿道受刺激或有炎症反应。
(3)其它包括非晶形尿酸盐或磷酸盐团;细胞团;其它异物如棉,毛,麻的纤维,毛发及玻片上的纹痕等,均应与管型鉴别。